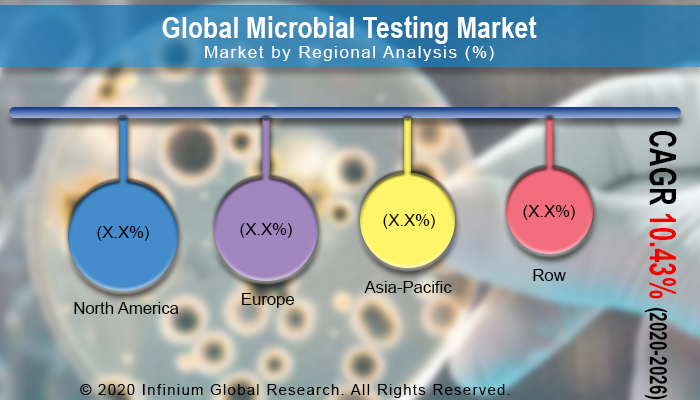
Microbial Testing Market

Microbial Testing Market (Product - Instruments, and Reagents): Global Industry Analysis, Trends, Size, Share and Forecasts to 2026
A recent report published by
Infinium Global Research on the microbial testing market provides an in-depth analysis
of segments and sub-segments in the global as well as the regional microbial
testing market. The study also highlights the impact of drivers, restraints,
and macro indicators on the global and regional microbial testing market over
the short term as well as long term. The report is a comprehensive presentation
of trends, forecasts, and dollar values of the global microbial testing market.
According to the report, the global microbial testing market is projected to
grow at a CAGR of 10.43% over the forecast period of 2020-2026.
Market Insight
Microbial testing is vital for
contamination detection and maintaining high-quality standards. It is the first
line of defense against disease-causing bacteria and toxins and supporting
public health. Microbial testing can help prevent the spread of dangerous
bacteria that could lead to serious illness or even death. Food testing, water
testing, pharmaceutical testing, and USP testing are just a few microbial testing
services by the major players operating in the market. Several sectors such as
the healthcare facilities, food industry and restaurants, laboratories, and
other industries greatly benefit from these microbial tests. The microbial
testing service providers will experience a decrease in demand due to the current
COVID-19 pandemic. Currently, as the entire health care system is primarily
focused on treating and developing vaccines for this virus, the major microbial
testing service providers across the globe will experience a reduction during the
2020 COVID-19 outbreak. However, the rising government funding in R&D to
control and contain the virus is also anticipated to drive the volume of
microbial testing in research facilities.
In recent years, awareness among
consumers for the safety of products they consume has increased manifold.
Moreover, the relatively high occurrence of outbreaks of foodborne diseases in
many countries, including developed ones, has resulted in increasing concern
and intensive investigation of foodborne pathogens. As a result, increased
demand for the microbiological testing of food products is witnessed in the
market currently. Furthermore, Brazil, Russia, India, China, and South Africa
are experiencing a rapid economic growth and are facing a growing aging
population and an increasing prevalence of infectious diseases. Moreover, the
health care spending share of the BRICS nations are growing and the rising
healthcare expenditure and the growth of medical infrastructures in these countries
are projected to augment the growth of the market. However, shortage of skilled
workforce is likely to impede the growth of microbial testing market.
Nevertheless, the advances and innovations in microbial diagnostic technologies
are projected to have a significant impact on the growth of the microbial
testing market.
Among the regions, North America
held the largest market share in the global microbial testing market with the
US being the key revenue generator and the country has remained a world leader
in diagnostic technology innovation. Nevertheless, the Asia-Pacific market will
expand with the most prominent CAGR in the anticipated time. China, India and
South Korea will experience the strongest gains in the market as capital, jobs
and research gravitate toward these growing markets. Asia Pacific market is
also expected to expand as water quality monitoring in developing Asia Pacific
countries such as India, China, Malaysia, Mongolia, Myanmar, Nepal,
Philippines and Sri Lanka are on the rise.
Segment Covered
The report on the global microbial
testing market covers segments such as product. On the basis of product, the
sub-markets include instruments, and reagents.
Companies Profiled:
The report provides profiles of
the companies in the market such as Becton Dickinson, Biomerieux, Thermo Fisher
Scientific, Beckman Coulter, 3M Company, AEMTEK Laboratories, Bio-Rad
Laboratories Inc., SGS SA, ALS life Sciences, and Vivione Bioscience.
Report Highlights:
The report provides deep insights
into the demand forecasts, market trends, and micro and macro indicators. In
addition, this report provides insights into the factors that are driving and
restraining the growth in this market. Moreover, The IGR-Growth Matrix analysis
given in the report brings an insight into the investment areas that existing
or new market players can consider. The report provides insights into the
market using analytical tools such as Porter's five forces analysis and DRO
analysis of the microbial testing market. Moreover, the study highlights current
market trends and provides forecasts from 2020-2026. We also have highlighted
future trends in the market that will affect the demand during the forecast
period. Moreover, the competitive analysis given in each regional market brings
an insight into the market share of the leading players.
